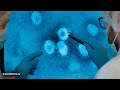

None
Qué TAN PELIGROSO Es Para Los HUMANOS El NUEVO VIRUS GIGANTE DESCUBIERTO En Lo PROFUNDO Del MAR? ─ Tu COSMOPOLIS
<style>.embed-container { position: relative; padding-bottom: 56.25%; height: 0; overflow: hidden; max-width: 100%; } .embed-container iframe, .embed-container object, .embed-container embed { position: absolute; top: 0; left: 0; width: 100%; height: 100%; }</style><div class="embed-container"><iframe src="https://www.youtube.com/embed/6cipbuVIP1E" frameborder="0" allowfullscreen></iframe></div>